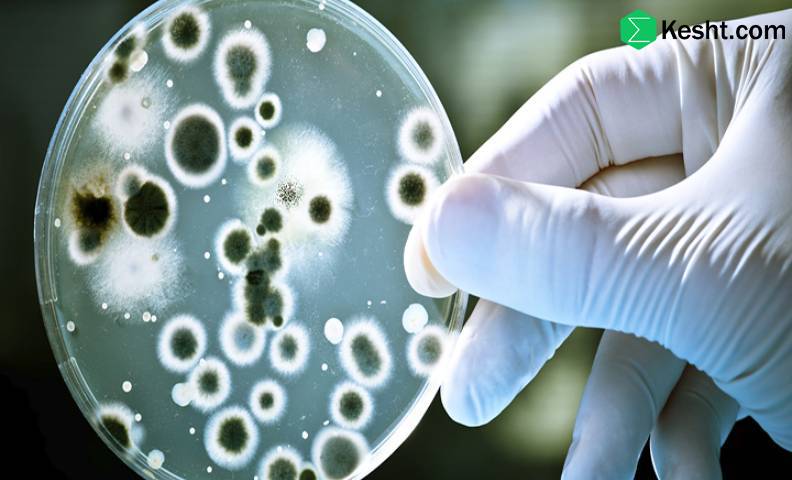
روش های تست میکروبی نهال ها

هزینه راه اندازی آزمایشگاه کشت بافت چقدر است؟
هزینه راهاندازی یک آزمایشگاه کشت بافت میتواند به عوامل متعددی بستگی داشته باشد، از جمله:
۱. تجهیزات اولیه
- کابینت هود میکروبی: بین ۵۰۰۰ تا ۲۰۰۰۰ دلار
- انکوباتور: ۲۰۰۰ تا ۱۰۰۰۰ دلار
- جعبههای کشت بافت: ۱۰۰۰ تا ۳۰۰۰ دلار
- میکروپایپتها و ملزومات: ۵۰۰ تا ۲۰۰۰ دلار
۲. مواد مصرفی
- محیطهای کشت: هزینه این مواد بسته به نوع و کیفیت میتواند بین ۱۰۰ تا ۵۰۰ دلار در هر ماه باشد.
- هورمونها و ویتامینها: هزینه اولیه حدود ۵۰۰ تا ۲۰۰۰ دلار.
۳. فضا و تأسیسات
- اجاره یا خرید فضا: هزینه به موقعیت جغرافیایی و اندازه آزمایشگاه بستگی دارد و میتواند بین ۵۰۰ تا ۵۰۰۰ دلار در ماه باشد.
- سیستمهای تهویه و کنترل دما: هزینه نصب و راهاندازی میتواند بین ۱۰۰۰ تا ۵۰۰۰ دلار باشد.
۴. نیروی انسانی
- هزینههای استخدام: بسته به تخصص و تجربه، هزینههای حقوق میتواند از ۲۰۰۰ تا ۷۰۰۰ دلار در ماه برای هر فرد باشد.
۵. هزینههای عمومی
- برق، آب و سایر هزینهها: معمولاً بین ۲۰۰ تا ۸۰۰ دلار در ماه.
تخمین کلی
با توجه به موارد فوق، هزینه کلی راهاندازی یک آزمایشگاه کشت بافت میتواند بین ۲۰۰۰۰ تا ۱۰۰۰۰۰ دلار یا بیشتر باشد، بسته به مقیاس و تجهیزات مورد استفاده.
برای راهاندازی دقیق تر، بهتر است با متخصصان این حوزه مشورت کنید و برآورد دقیقتری از هزینهها داشته باشید.
در صورت تمایل پیشنهاد میشود مقاله زیر را مطالعه فرمایید : روش های تست میکروبی نهال ها
هزینه راه اندازی یک آزمایشگاه کشت بافت کوچک چقدر است؟
هزینه راهاندازی یک آزمایشگاه کشت بافت کوچک میتواند به عوامل مختلفی بستگی داشته باشد، اما به طور کلی میتوان آن را به چند بخش تقسیم کرد.
در زیر تخمین هزینههای مربوط به هر بخش ارائه شده است:
۱. تجهیزات اصلی
- کابینت هود میکروبی: ۵۰۰۰ تا ۱۵۰۰۰ دلار
- انکوباتور: ۲۰۰۰ تا ۷۰۰۰ دلار
- میکروسکوپ: ۱۰۰۰ تا ۵۰۰۰ دلار
- محیطهای کشت و ملزومات: ۵۰۰ تا ۲۰۰۰ دلار
۲. مواد مصرفی
- محیطهای کشت: ۱۰۰ تا ۵۰۰ دلار در ماه
- هورمونها و ویتامینها: ۵۰۰ تا ۱۵۰۰ دلار
۳. فضای آزمایشگاه
- اجاره یا خرید فضا: ۳۰۰ تا ۱۵۰۰ دلار در ماه بسته به موقعیت جغرافیایی
- تأسیسات و زیرساختها (برق، آب و غیره): ۱۰۰۰ تا ۵۰۰۰ دلار
۴. نیروی انسانی
- هزینههای استخدام: بسته به تخصص، ۲۰۰۰ تا ۵۰۰۰ دلار در ماه برای هر فرد
۵. هزینههای عمومی
- برق، آب و سایر هزینهها: ۲۰۰ تا ۵۰۰ دلار در ماه
در صورت تمایل پیشنهاد میشود مقاله زیر را مطالعه فرمایید : تأمینکنندگان تجهیزات آزمایشگاهی
https://ekesht.com/fa/%D9%85%D9%82%D8%A7%D9%84%D9%87/suppliers-of-laboratory-equipment
تخمین کلی
با توجه به موارد فوق، هزینه کل راهاندازی یک آزمایشگاه کشت بافت کوچک میتواند در حدود **۲۰۰۰۰ تا ۷۰۰۰۰ دلار** یا بیشتر باشد، بسته به تجهیزات و شرایط خاص محل.
نکات نهایی
- برنامهریزی دقیق: بررسی دقیق نیازها و بودجهریزی مناسب میتواند به کاهش هزینهها کمک کند.
- مشاوره با متخصصان: مشورت با افرادی که تجربه راهاندازی آزمایشگاه دارند میتواند مفید باشد.
برای یک آزمایشگاه با ظرفیت 100 کشت، چه تجهیزاتی لازم است؟
برای راهاندازی یک آزمایشگاه کشت بافت با ظرفیت 100 کشت، تجهیزات زیر ضروری هستند:
تجهیزات اصلی
1. کابینت هود میکروبی
- برای حفظ شرایط استریل و جلوگیری از آلودگی.
2. انکوباتور
- برای کنترل دما و رطوبت، و فراهم کردن شرایط مناسب برای رشد نهالها.
3. میکروسکوپ
- برای بررسی و شناسایی نمونهها.
4.کوره استریل (Autoclave)
- برای استریل کردن ابزار و محیطهای کشت.
5.دوغابساز (Homogenizer)
- برای تهیه محیطهای کشت و مخلوط کردن مواد.
ملزومات کشت
1. محیطهای کشت
- شامل انواع ژل آگار و محیطهای مایع برای کشت.
2. هورمونهای گیاهی
- مانند آکسینها، سیتوکینینها و جیبرلین برای تحریک رشد.
3. لوازم جانبی
- شامل لولههای آزمایشگاهی، پیپتها، پتری دیشها و ظروف کشت.
تجهیزات جانبی
1. سیستم تهویه
- برای حفظ کیفیت هوا و کنترل دما.
2. چرخ دستی یا میز کار
- برای سازماندهی و آسان کردن دسترسی به تجهیزات.
3. سیستم نورپردازی
- اگر نیاز به نور طبیعی یا مصنوعی برای گیاهان باشد.
4. دستگاههای اندازهگیری
- شامل pH متر و دستگاههای اندازهگیری دما و رطوبت.
هزینهها
- با توجه به تجهیزات فوق، هزینهها میتواند متفاوت باشد، اما معمولاً هزینه کل برای تجهیزات اولیه برای آزمایشگاه با ظرفیت 100 کشت بین **۲۰,۰۰۰ تا ۵۰,۰۰۰ دلار** یا بیشتر خواهد بود.
انتخاب تجهیزات مناسب و برنامهریزی دقیق برای نیازهای خاص آزمایشگاه میتواند به افزایش کارایی و موفقیت کشتها کمک کند.
در صورت تمایل پیشنهاد میشود مقاله زیر را مطالعه فرمایید : کتاب های باغبانی
https://ekesht.com/fa/%D9%85%D9%82%D8%A7%D9%84%D9%87/gardening-books-of-iran
پانزده سال تجربه تجارت عملی و موفقیت آمیز با کشورهای روسیه،قزاقستان،عراق،چین،ترکمنستان،ترکیه و ...
لیستی از تامین کنندگان تجهیزات کشت بافت در ایران
در ایران، چندین تأمینکننده و شرکت وجود دارند که تجهیزات و ملزومات کشت بافت را ارائه میدهند. در زیر به برخی از این تأمینکنندگان اشاره میشود:
۱. شرکتهای تخصصی تجهیزات آزمایشگاهی
- شرکتهای واردکننده تجهیزات آزمایشگاهی: بسیاری از این شرکتها تجهیزات کشت بافت، از جمله کابینتهای هود میکروبی و انکوباتورها را تأمین میکنند.
۲. شرکتهای تولیدکننده محیطهای کشت
- شرکتهای تولیدکننده محیطهای کشت: این شرکتها معمولاً انواع محیطهای کشت و مواد مورد نیاز برای کشت بافت را تولید و عرضه میکنند.
۳. فروشگاههای آنلاین و سایتهای تخصصی
- برخی وبسایتهای آنلاین نیز تجهیزات و مواد مورد نیاز برای کشت بافت را به فروش میرسانند. جستجو در این وبسایتها میتواند به شما در پیدا کردن تأمینکنندگان کمک کند.
۴. نمایشگاهها و همایشها
- شرکت در نمایشگاهها و همایشهای مرتبط با کشاورزی و علوم زیستی میتواند فرصت خوبی برای آشنایی با تأمینکنندگان و محصولات جدید باشد.
۵. مشاوره با دانشگاهها و مراکز تحقیقاتی
- ارتباط با دانشگاهها و مراکز تحقیقاتی که در زمینه کشت بافت فعالیت میکنند، میتواند به شما در شناسایی تأمینکنندگان معتبر کمک کند.
برای تأمین تجهیزات و ملزومات کشت بافت، بهتر است از طریق منابع مختلف تحقیق کنید و با تأمینکنندگان مختلف ارتباط برقرار کنید تا بهترین گزینهها را پیدا کنید.
امیدوارم اطلاعات مفیدی در اختیار شما قرار داده باشیم و در راستای هموار کردن مسیر شا قدمی برداشته باشیم.
شرکت ثمین اطلس ایرانیان آماده همکاری با افراد فعال در حوزه کشاورزی میباشد
برای اطلاعات بیشتر وتکمیلی لطفا از طریق سوشیال مدیا یا تماس تلفنی با ما در ارتباط باشید
شماره تلفن:
ایمیل:
سوشیال مدیا: